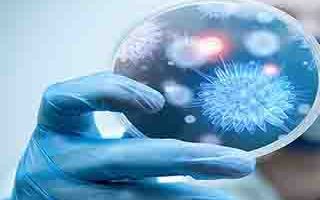

آشنایی با بیماری هاری
در نمایش آنلاین پاورپوینت، ممکن است بعضی علائم، اعداد و حتی فونتها به خوبی نمایش داده نشود. این مشکل در فایل اصلی پاورپوینت وجود ندارد.
- جزئیات
- امتیاز و نظرات
- متن پاورپوینت
برچسبهای مرتبط
- آشنایی با بیماری هاری
- اهمیت بیماری هاری
- بیماری هاری
- پاورپوینت
- پاورپوینت آشنایی با بیماری هاری
- پاورپوینت آماده
- پاورپوینت بیماری هاری
- پاورپوینت رایگان
- پیشگیری از ابتلا به هاری
- پیشگیری از حیوان گزیدگی
- تاریخچه بیماری هاری
- تشخیص هاری در انسان
- تشخیص هاری در حیوان
- دانلود پاورپوینت
- دانلود پاورپوینت آماده
- دانلود پاورپوینت رایگان
- راه های سرایت بیماری هاری
- عامل بیماری هاری
- علائم بالینی هاری در انسان
- علائم بیماری هاری
- علائم بیماری هاری در حیوان
امتیاز
آشنایی با بیماری هاری
اسلاید 1: هاریwww.iehe.ir
اسلاید 2: www.iehe.ir
اسلاید 3: بیماری هاری یکی از مهم ترین بیماریهای مشترک بین انسان و حیوان است که در خیلی از مناطق جهان شایع بوده و در ایران نیز یک اولویت مهم به شمار می آید. با وجود این که در ایران میلیاردها ریال جهت درمانْ پیشگیری از هاری هزینه می شود متأسفانه سالانه نزدیک به ده مورد مرگ غم انگیز و وحشتناک هاری را تجربه می نمایند. بیماری هاری در تمام نقاط جهان به جز استرالیا و قطب جنوب دیده می شود.www.iehe.ir
اسلاید 4: تاریخچه بیماری هاریبیماری هاری از 3هزار سال قبل ازمیلاد مسیح مورد شناخت انسان بوده است ؛ همچنین ذیمقراطیس (Democritus) ، طبیب و فیلسوف یونانی ، در 500 سال قبل از میلاد مسیح بیماری هاری را در سگ شرح داده است. مطالعات سیستماتیک در زمینه هاری و ایجاد بیماری تجربی را می توان با نام Zinke در سال 1804 و Refferschied در سال 1813 آغاز نمود . این دو محقق با تزریق بزاق آلوده سگ توانسته اند بیماری را به سگ های سالم منتقل نمایند. در سال 1812 لوئی پاستور نشان داد که مرکز عفونت در اعصاب مرکزی است .www.iehe.ir
اسلاید 5: حساسیت میزبانهای متعدد در حیوانات مختلف (گوشتخواران ، علفخواران و خفاشها) اهلی و وحشی موجب گسترش وسیع بیماری شده و علاوه بر اهمیت بهداشتی و اقتصادی ، مشکلات عمده ای را در پیشگیری و کنترل بیماری موجب گردیده است .www.iehe.ir
اسلاید 6: اهمیت بیماری هاری میزان کشندگی بالا (100%) به طوری که پس از ظهور علائم بالینی چه در انسان و چه در حیوان، قابل درمان نبوده و بیمار محکوم به مرگ خواهد بود.افزایش روند موارد حیوان گزیدگی در انسان، به طوری که به ناچار سالانه مبالغ زیادی صرف خرید سرم و واکسن ضدهاری جهت درمان پیشگیری آسیب دیدگان می شود.تلفات دام و خسارتهای اقتصادی ناشی از این بیماری که در دام ها ایجاد می شود.از آنجا که درمان در مواردی به کار می رود که عامل بیماری وارد بدن فرد بیمار شده باشد و بیمار علائم بیماری را بروز داده باشد و از طرفی پیشگیری قبل از وقوع حادثه است ؛ در خصوص بیماری هاری و حیوان گزیدگی از آنجا که حادثه واقع شده ولی هنوز علائم بیماری ظاهر نشده است اصطلاح درمانْ پیشگیری از هاری پیشنهاد شده است.www.iehe.ir
اسلاید 7: عامل بیماری عامل هاری، ویروسی از گروه RNA و نروتروپ متعلق به رابدوویروس ها و جنس لیساویروس ها ست . رابدوویروس ها شبیه فشنگ بوده ، در یک انتها مسطح و در انتهای دیگر محدب و از دو قسمت زیر تشکیل شده است:گلیکوپروتئینریبونوکلئوپروتئینماتریکس (ماده زمینه ای)غشای خارجیwww.iehe.ir
اسلاید 8: قسمت مرکزی: شامل ریبونوکلئوپروتئین فشردة مارپیچی با ژنوم RNA بوده که به وسیله غشای خارجی احاطه شده است. در این قسمت دو پروتئین دیگر شامل فسفوپروتئین و پلی مراز نیز به ریبونوکلئوپروتئین متصل است.غشای خارجی: از جنس لیپوپروتئین و دارای دو پروتئین ماتریکس و گلیکوپروتئین است ، گلیکوپروتئین ها برجستگی های سوزنی شکلی هستند که محکم روی غشای خارجی چسبیده اند و در اتصال ویروس به سلول میزبان و تولید آنتی بادی خنثی کننده نقش دارند. غشای دو لایه ایریبونوکلئوپروتئینماتریکس پروتئینیRNAwww.iehe.ir
اسلاید 9: مراحل تکثیر ویروس ویروسها فقط قادرند در یک سلول زنده تکثیر یابند و از روش دو تایی (که در مورد اغلب میکروارگانیسم ها ست) تبعیت نمی کند ؛ تکثیر ویروس از 9 مرحله تشکیل شده استwww.iehe.ir
اسلاید 10: در واقع، هاری یک عفونت حاد سیستم عصبی مرکزی است که تقریباً همیشه کُشنده است . این بیماری مخصوص گوشتخواران اهلی و وحشی بوده ، موجب انسفالومیلیت در انسان و همه پستانداران خون گرم (گرگ، سگ، گربه ، الاغ ، گاو، اسب و...) می شود. www.iehe.ir
اسلاید 11: راه های سرایت بیماری هاری به حیوان و انسان گاز گرفتن : اصلی ترین راه سرایت بیماری، گازگرفتن به وسیله حیوان هار است. پنجه کشیدن : پنجه آغشته به بزاق حاوی ویروس به ویژه در گربه و گربه سانان که عادت به لیس زدن پنجه های خود دارند نیز ایجاد بیماری می کند. پوست : از طریق پوست سالم ، سرایت پذیر نیست؛ ولی از راه کوچکترین خراش یا زخم در پوست ، این بیماری منتقل می شود. نسوج مخاطی: انسان و حیوان های به ظاهر سالم که در اواخر دوره نهفتگی بیماری هستند و هنوز علائم بالینی هاری در آن ها ظاهر نشده است، از طریق لیسیدن لب، چشم و بینی افراد و کودکانی که با آن ها بازی می کنند بیماری هاری را انتقال می دهند . دستگاه گوارش: انتقال از این راه بعید است ؛ به هر حال باید از خوردن گوشت و فرآورده های دام های مبتلا به هاری خودداری کرد.ادامه داردwww.iehe.ir
اسلاید 12: پنجه گربه حتی در حد خراش نیز می تواند موجب انتقال بیماری هاری گردد ؛ چراکه گربه عادت به لیسیدن پنجه های خود دارد لذا لازم است فوری نسبت به درمان پیشگیری از هاری(شستشوی زخم و واکسیناسیون) اقدام نمود. ادامه دارد ویروس هاری حتی از زخم های بسیار کوچک و در حد خراش هم می تواند باعث هار شدن فرد گردد ؛ پس زخم هر چند کوچک (حتی خراش پوستی ) بایستی فوری تحت درمانْ پیشگیری از هاری (شستشوی زخم و واکسیناسیون) قرار گیردwww.iehe.ir
اسلاید 13: راه های سرایت بیماری هاری به حیوان و انسان (ادامه) تنفس: آلودگی از طریق تنفس به ویژه در غارهای محل زندگی خفاش های آلوده ، امکان پذیر است؛ لازم به ذکر است تا کنون در ایران خفاش آلوده گزارش نشده است. جفت: انتقال هاری از طریق جفت نیز بعید نیست. وسایل آلوده: ویروس هاری بسیار حساس است و در مقابل نور و خشکی به سرعت از بین می رود ؛ لذا هاری از طریق وسایل آلوده فقط در موارد استثنایی منتقل می شود. انسان به انسان: الف) تا به حال موارد معدودی از طریق پیوند اعضا در دنیا گزارش شده است. ب) در ایران دو پیوند قرنیه در سال 1373 مسبب انتقال انسان به انسان هاری بوده است. ج) در پاکستان ابتلاء تعدادی نوزاد به هاری ناشی از آلودگی شخص ختنه کننده به ظاهر سالم بوده است که طبق سنت ، محل ختنه را به بزاق خود آغشته کرده بود.www.iehe.ir
اسلاید 14: علائم بیماری هاریwww.iehe.ir
اسلاید 15: علائم بیماری هاری در انسان و حیوانات مشابه می باشد که مانند هر بیماری دیگر دارای مراحل زیر است:دوره نهفتگی (دوره کمون ) بروز علائم اولیه بیماری بروز علائم پیشرفته بیماری مدت زمان مراحل فوق در هر انواع جانداران حساس به بیماری متفاوت می باشد ؛ از طرفی هاری به اشکال مختلف ظاهر می شود:هاری آرام ، ساکت یا شکل فلجی بیماریهاری خشمگین www.iehe.ir
اسلاید 16: علائم بیماری هاری در حیوانذکر این نکته ضروری است که در بین حیوانات بیشتر تحقیقات بر روی سگ و گربه صورت پذیرفته است و اطلاعات کافی در خصوص دوره نهفتگی ، زمان آلوده کنندگی ویروس و ... جهت سایر حیوانات در دست نمی باشد . دوره نهفتگی : ( مدت زمان ورود ویروس به بدن تا بروز اولین علائم بیماری ) این دوره برحسب عمق ، سطح ، محل و سایر مشخصات زخم متفاوت می باشد ، در سگ و گربه 3-2 هفته و گاهی تا چند ماه است .نکته : ویروس موجود در بزاق سگ یا گربه 3 تا 10 روز قبل از بروز علائم بیماری (اواخر دوره نهفتگی ) می تواند آلوده کننده باشد ، به عبارت دیگر اگر بزاق سگ یا گربه در زمان گازگرفتن به ویروس هاری آلوده باشد ، علائم بالینی حداکثر تا 10 روز بعد، در حیوان ظاهر شده و خواهد مرد. ادامه داردwww.iehe.ir
اسلاید 17: بایستی هرنوع حیوان گزیدگی را هار گزیدگی تلقی نموده بلافاصله اقدامات درمانْ پیشگیری (شستشوی زخم و واکسیناسیون ) را بکار برداز آنجا که در صورت حمله و هجوم حیوان به انسان ممکن است حیوان مهاجم آلوده به ویروس هاری ودر اواخر دوره کمون(زمانی که ویروس قدرت آلوده کنندگی را دارد ) بوده و ظاهری سالم داشته باشد ؛ لذا چراکه تا زمان بروز علائم بیماری در حیوان ممکن است دیگرفرصتی برای نجات انسان نباشد ادامه داردwww.iehe.ir
اسلاید 18: علائم بیماری هاری در حیوان (ادامه)بروز علائم اولیه بیماری: پس از طی دوره نهفتگی ، اولین علامت بیماری ، تغییر در رفتار و عادت های حیوان است؛ به نحوی که:یا بیش از اندازه به صاحب خود انس و الفت پیدا می کند و مثل این که از او کمک می طلبد یا عصبانی و بدخو شده ، غذای خود را به دلیل اختلال در بلع به خوبی نمی خوردwww.iehe.ir
اسلاید 19: علائم بیماری هاری در حیوان (ادامه)بروز علائم پیشرفته بیماری : پیشرفت بیماری به ممکن است به یکی از دو شکل زیر باشد:شکل فلجی (هاری ساکت): حیوان به گوشه ای پناه می برد و ابتدا دستها و سپس پاها و بعد سایر اندامها فلج شده و در نهایت به علت فلج دستگاه تنفسی می میرد ؛ ولی کم کم وحشی و درنده (هاری خشمگین) می شودهاری خشمگین: حیوان به گاز گرفتن سنگ و چوب و اشیای مختلف پرداخته و محل زندگی خود را ترک می کند و بدون هدف به هر جایی می رود و به هر کس و هر حیوان سرراه خود حمله می برد . در نهایت پس از مدتی در اثر دوندگی زیاد و گرسنگی و تشنگی به علت عدم قدرت بلع ، کف از دهانش سرازیر شده و پی در پی زمین می خورد . صدای پارس حیوان خشن ، ناموزون و بریده بوده و درندگی در چهره اش هویداست ؛ بالاخره در اثر فلج دستگاه تنفسی خواهد مُرد.www.iehe.ir
اسلاید 20: ویروس هاری خود را به عصب رسانده و از آنجا به بزاق حیوان راه می یابد.www.iehe.ir
اسلاید 21: علائم بالینی هاری در انساندوره نهفتگی : در انسان نیز طول دوره نهفتگی به شدت زخم ، تعداد جراحت و محل آن ها بستگی دارد ، در واقع محل جراحت هرچه به عصب مرکزی (مغز و نخاع) نزدیکتر باشد طول دوره نهفتگی کوتاهتر خواهد بود؛ به نحوی که گاز گرفتن صورت زودتر موجب بروز علائم بیماری می شود ؛ این مرحله به طور معمول در انسان 15 روز تا 3 ماه به طول می انجامد ، ولی از چند روز تا چند سال هم مشاهده شده است. www.iehe.ir
اسلاید 22: علائم بالینی هاری در انسان (ادامه)بروز علائم اولیه بیماری: علائم اولیه خود شامل علائم غیراختصاصی و علائم اختصاصی بروز می یابد.علائم غیر اختصاصی: این مرحله حداکثر 10 روز به طول می انجامد . تب ، لرز، خستگی ، سردرد، ضعف و درد عضلانی ، بی اشتهایی، اشکال در بلع، حالت تهوع و استفراغ، سرگیجه ، دردهای شکمی و اسهال، گلودرد، تنگی نفس ، سرفه خشک، نگرانی و ترس، تحریک پذیری و عصبی بودنعلائم بسیار اختصاصی: علائم موضعی در محل گازگرفتن شامل : سوزش ، گزگز و مورمور (در 50 تا 80 درصد بیماران) ، این علائم در مسیر عصب حسی عضو گاز گرفته شده نیز به علت تکثیر ویروس در ریشه خلفی عصب حسی بروز می کند. www.iehe.ir
اسلاید 23: علائم بالینی هاری در انسان (ادامه)بروز علائم پیشرفته بیماری یا مرحله حاد عصبی: این مرحله احتمالاً بسته به سوش ویروس به دو شکل ظاهر می شود:شکل ساکت یا فلجی: این شکل بیماری کمتر شایع است (20% موارد هاری) ، مهمتر این که در اغلب موارد تشخیص داده نمی شود . علائم این شکل شامل : ضعف در اندام گاز گرفته شده و به تدریج در سایر اعضاء و عضله های صورت ، کاهش هوشیاری و اختلال در حس ، فلج پایین رونده (مشابه سندرم گیلن باره) یا فلج چهار عضو به طور قرینه ، ممکن است سردرد و سفتی گردن (نشانه های مننژه) اتفاق افتد و در نهایت ، بیمار دچار خواب آلودگی و کما می شود . گاهی بیماری به شکل هیجانی تغییر می یابد.www.iehe.ir
اسلاید 24: علائم بالینی هاری در انسان (ادامه)شکل تحریکی، هیجانی یا خشمگین: علائم فعالیت حرکتی شدید شامل دویدن و دست و پا زدن ، تحریک پذیری و عدم آرامش، توهم ، نگرانی و هیجان ، مشخصه این شکل بیماری است . ترس از آب ، علامتی است که در این شکل در بیشتر موارد دیده می شود . همچنین نسیم ملایم ، نور شدید ، صدای بلند و لمس کردن ممکن است موجب تحریک پذیری و انقباض عضله های تنفسی می شود . افزایش ترشح بزاق و اختلال در بلع موجب شکل مشخص بیماری هاری می شود . خواب آلودگی ، توهم، حالت تهاجم ، انقباض های عضلانی ، علائم مننژیت ، تشنج و فلج موضعی به سرعت ظاهر می شود . اختلال های خُلقی دوره ای ایجاد می شود و با پیشرفت بیماری ، تا زمانی که بیمار وارد کما شود دوره های سلامت کوتاه می شود . www.iehe.ir
اسلاید 25: در هاری خشمگین بدلیل هجوم فرد بیمار به اطرافیان چاره ای جز بستن دست ها و پاهای وی نمی باشدwww.iehe.ir
اسلاید 26: علائم بالینی هاری در انسان (ادامه)در معاینه ، درجه حرارت بدن ممکن است بیش از°c40 باشد. گشاد شدن نامنظم مردمک ، افزایش ترشح اشک، بزاق ، تعریق و کاهش فشار خون دیده می شود ؛ همچنین شواهد فلج اعصاب حرکتی فوقانی (ضعف ، افزایش واکنش تاندون های عمقی و واکنش کف پایی مثبت ) همیشه وجو د داشته ، فلج تارهای صوتی ، دوبینی ، فلج عضلات صورت و نوریت عصب اُپتیک نیز مشاهده می شود. افزایش تعداد تنفس و حتی آپنه دیده می شود ؛ اختلال ریتم قلب شایع بوده و به خصوص تاکی کاردی فوق بطنی و برادی کاردی به دلیل اختلال فعالیت پایه های مغز یا میوکاردیت اتفاق می افتد. در اکثر موارد ، بیماران طی یک تا دو هفته چار کما شده و با وجود مراقبت های شدید به دلیل نارسایی تنفس یا کلاپس قلبی عروقی فوت می کنند.www.iehe.ir
اسلاید 27: علائم بالینی هاری در انسان (ادامه) مرحله کما و مرگدر نهایت ابتلا به بیماری هاری به مرحله کما می رسد و بیمار یه علت نارسایی یا کلاپس قلب عروقی می میرد.از شروع علائم بالینی تا مرگ به طور متوسط 4 تا 7 روز طول می کشد . در موارد نادر با مراقبت های شدید از بیماران ، طول عمر بیشتر می شود ؛ ولی عوارض دیر رس شامل ترشح ناکافی هورمون آنتی دیورتیک ، دیابت بی مزه ، اختلال در ریتم قلبی ، عدم استحکام عروقی، سندرم نارسایی تنفسی بالغین (ARDS) ، خونریزی گوارشی ، کاهش پلاکت ها و ایلئوس پارالیتیک ایجاد می شود.www.iehe.ir
اسلاید 28: طول مدت مراحل مختلف هاری در پایان دوره نهفتگی ، ویروس هاری به محل اتصال عصب و عضله یا انتهای اعصاب حرکتی سطحی نفوذ کرده و به طرف نخاع و سیستم اعصاب مرکزی حرکت می کندwww.iehe.ir
اسلاید 29: www.iehe.ir
اسلاید 30: www.iehe.ir
اسلاید 31: تشخیص های افتراقیسایر آنسفالیت های ویروسی، کزاز ، آنسفالیت سمی، آنسفالیت آلرژیک، سندرم گیلن باره ، پولیومیلیت و سایر نوروپاتی ها و میلوپاتی ها ، پلی نوروپاتی التهابی ، میلیت عرضی و واکنش های روانی به دنبال گاز گرفتن حیوان (ترس کاذب از آب) ، در تشخیص افتراقی بیماری هاری مطرح هستند.ظهور اختلال فعالیت پایه های مغزی در مراحل اولیه ، وجه افتراق هاری از سایر آنسفالیت های ویروسی بوده که نشان دهنده وخامت بیماری است و علائم آن عبارتند از : دوبینی، فلج عضله های صورت و نوریت عصب اُپتیک به دلیل گرفتاری اعصاب مغزی ، ترس از آب و ایجاد انقباض به دنبال بلع ، افزایش ترشح بزاق ، اشک، عرق و اختلال در بلع.www.iehe.ir
اسلاید 32: تشخیص آزمایشگاهیwww.iehe.ir
اسلاید 33: معیارهای تشخیص آزمایشگاهیروش FAT(تست فلوئور سنت آنتی بادی) در نمونه های زیر:بافت مغز تهیه شده پس از مرگلام پوست ناحیه گردن یا قرنیه ، قبل از مرگبعد از تزریق بافت مغز ، بزاق یا مایع نخاعی در کشت سلول یا موش، بررسی نمونه های مغز از نظر وجود اجسام نگری به خصوص در سلول های هرمی هیپوکامپروش PCR روی نمونه بافت مغز تهیه شده پس از مرگ یا در نمونه کلینیکی (پوست ، قرنیه یا بزاق)یافتن تیتر آنتی بادی نوترالیزان هاری در سرم و مایع نخاعی افراد غیر واکسینهwww.iehe.ir
اسلاید 34: تشخیص در حیواننمونه برداری از حیوان مهاجم : به منظور تشخیص بیماری هاری در حیوان مهاجم و مشکوک می توان از دو روش استفاده کرد:کشتن حیوان مشکوک و ارسال سر آن به انستیتو پاستور ایران نمونه برداری از بافت مغز با استفاده از کیت های مخصوص نمونه برداری و ارسال به انستیتو پاستور ایران نکته: در استان يزد معمولا روش دوم صورت می پذیرد زنده یا اجساد حیوانات مشکوک به اداره کل دامپزشکی ارسال و پس از نمونه گیری توسط همکاران آن اداره کل ، نمونه بافت مغز به انستیتو پاستورایران ارسال می گردد.www.iehe.ir
اسلاید 35: در صورت مشاهده فرد حیوان گزیده از وضعیت و محل حیوان مهاجم جویا شده و چنانچه حیوان ، تلف یا کشته شده است ؛ توصیه گردد جسد حیوان را در جای خنک و سایه نگهداری نموده ؛ لازم است حتی الامکان در همان ساعات اولیه، مرکز بهداشت استان (7247080) مطلع گردد. www.iehe.ir
اسلاید 36: تشخیص در انسانWBC(گلبول سفید خون): افزایش مختصری خواهد داشت.بررسی مایع نخاعی (در تعداد معدودی از بیماران غیر طبیعی است)شامل:افزایش لنفوسیت ها (5 تا 30 سلول در میلی متر مکعب)افزایش مختصر پروتئین (کمتر از mg/dl 100(نکته : محل های نمونه گیری در انسان نیز مانند حیوان است.www.iehe.ir
اسلاید 37: تعاریف و طبقه بندیwww.iehe.ir
اسلاید 38: تعاریف و طبقه بندی انسان مبتلا به هاریمورد مشکوک: دارای علائم کلینیکی شامل ظهور ناگهانی علائم عصبی به شکل هیجانی از قبیل تحریک پذیری، تشنج، ترس از آب ، ترس از نور ، افزایش ترشح بزاق، اختلال در بلع و تنفس و یا شکل فلجی (بی سرو صدا) که بیمار به سرعت وارد کما شده و در مدت 10-7 روز فوت کند.مورد محتمل: وجود علائم مرحله مشکوک به اضافه سابقه تماس با حیوان مشکوک به هاری مورد قطعی: وجود علائم مرحله مشکوک به اضافه تشخیص و تأیید آزمایش اختصاصیwww.iehe.ir
اسلاید 39: تعاریف و طبقه بندی انسان در تماس با هاریتماس محتمل: شخصی که از طریق بزاق، گزش یا خراش یک حیوان حساس به هاری یا حیوانی از منطقه آلوده به هاری مورد مواجهه قرار گرفته است.تماس قطعی: شخصی که از طریق بزاق، گزش یا خراش یک حیوان با تشخیص قطعی هاری یا حیوان متواری شده مورد مواجهه قرار گرفته است.www.iehe.ir
اسلاید 40: درماندرماندرماندرماندرماندرماندرماندرماندرماندرماندرمانwww.iehe.ir
اسلاید 41: در صورت شروع علائم هاری، بیماری درمان پذیر نیستبا وجود مراقبتهای کامل، بیماران در طی یک تا دو هفته پس از شروع علائم می میرند . بیمار مبتلا به هاری باید در اتاق ایزوله تحت مراقبت های ویژه قرار گیرد؛ به ترتیب که پس از بستری کردن بیمار در یک اتاق کم نور در محلی بی سروصدا و ساکت و آرام، اقدام های ذیل را انجام داد:تزریق داروهای آرام بخش و ضد تشنججایگزینی مایعات و الکترولیتتزریق آنتی بیوتیک در صورت وجود عفونتبازنگه داشتن راه های تنفسیدرمان نارسایی تنفسی و قلبی عروقیwww.iehe.ir
اسلاید 42: ابتلا به هاری = مرگ حتمیابتلا به هاری = مرگ حتمیابتلا به هاری = مرگ حتمیابتلا به هاری = مرگ حتمیابتلا به هاری = مرگ حتمیwww.iehe.ir
اسلاید 43: اقدام های لازم در برخورد با بیمار مشکوک به هاری و موارد تماسwww.iehe.ir
اسلاید 44: استفاده از وسایل حفاظتی شامل: دستکش ، ماسک، گان، عینک و ... جهت کارکنان بیمارستان (پزشک، پرستار، خدمتگزاران و ...)، ملاقات کنندگان و سایر کسانی که به نحوی با بیمار در تماس هستندواکسیناسیون کامل هاری (5 نوبتی) در موارد زیر:کارکنانی که در مراقبت و درمان بیمار فعالیت دارندافراد در تماس مستقیم با بیمار ، مانند افراد خانوادهافراد در تماس غیر مستقیم با بیمار از طریق وسایل آلوده به ترشحاتاقدام های لازم در برخورد با بیمار مشکوک به هاری و موارد تماسwww.iehe.ir
اسلاید 45: اقدام های لازم در برخورد با بیمار مشکوک به هاری و موارد تماسسرم ضد هاری و واکسیناسیون کامل هاری (5 نوبتی) در موارد زیر:افراد در تماس که دارای زخم باز یا ترک در پوست هستندافرادی که در طی تماس با بیمار یا جسد دچار صدمه به پوست شده اندهرگونه تماس با ترشحات آنها (پوستی یا مخاطی و ...)ضد عفونی یا معدوم کردن وسایل آلوده به ترشحات بیمار دفن بهداشتی ویژه جسد افراد مبتلا به هاری : در این موارد باید جسد را پس از ضدعفونی در یک کیسه نایلونی ضخیم و نفوذناپذیر قرار داده و به طور عمقی دفن نمودwww.iehe.ir
اسلاید 46: پیشگیریراههای پیشگیری از بیماری هاریwww.iehe.ir
اسلاید 47: راههای پیشگیری از بیماری هاری (ادامه)پیشگیری از حیوان گزیدگی پیشگیری از ابتلا به هاری در صورت وقوع حیوان گزیدگیwww.iehe.ir
اسلاید 48: پیشگیری از حیوان گزیدگیجلوگیری از ورود وُحوش به اماکن انسانی با رعایت اصول بهداشتی و خودداری از ریختن زباله و پس مانده های غذایی در اطراف منازل منازل و گذرگاهها و معابر عمومیخودداری از نگهداری سگ ، گربه و ... در منزل، مگر در موارد استثنایی و با رعایت قوانین نگهداری حیوانات خانگیخودداری از تردد سگ های خانگی و صاحب دار در معابر عمومی و پارک هاجلوگیری از نزدیک شدن (بخصوص کودکان) به سگ های ولگردجلوگیری از نزدیک شدن به حیوانات ماده شیرده و دارای بچهخودداری از دویدن در مقابل سگ و سگ سانان (سگها به اجسامی که به سرعت از مقابل چشمانشان حرکت می کنند حمله می کنند)پرهیز از خیره نگاه کردن به چشمان حیواناتی از قبیل سگwww.iehe.ir
اسلاید 49: پیشگیری از حیوان گزیدگی (ادامه)اتلاف سگهای ولگرد راه دیگر پیشگیری از بیماری هاری و حیوان گزیدگی است ؛ اجرای این روش هماهنگی و همکاری های بین بخشی قوی را می طلبد. در حال حاضر کمیته اجرایی اتلاف سگهای ولگرد در استان قم با حضور نمایندگان شهرداری یا بخشداری ، نیروی انتظامی (تیر انداز) ، معاونت بهداشتی (بهداشت محیط) و محیط زیست ، با رهبری فرمانداری و تولی گری شهرداری (در شهر) و بخشداری (در روستا) فعالیت هایی را در حاشیه شهرها و روستاها انجام می دهند ، مسلماً عده ای از هموطنان صدای شلیک گلوله را در بعضی شب ها شنیده اند. این تیم شکایات مردمی درخصوص حضور حیوانات مزاحم در محله خود را که به شهرداری یا بخشداری گزارش شده است پیگیری می نمایند.www.iehe.ir
اسلاید 50: پیشگیری از ابتلا به هاری (در صورت وقوع حیوان گزیدگی)همان طور که گفته شد، در صورت بروز علائم هاری ، این بیماری درمان پذیر نبوده و سرانجام به مرگ منتهی می شود . البته افراد حیوان گزیده اگر بلافاصله و در اسرع وقت تحت اقدامات درمان پیشگیری از هاری قرار بگیرند می توانند از ابتلا به بیماری هاری رهایی یابند.نکته : با توجه به وضعیت اپیدمیولوژیک ایران، در تمام موارد حیوان گزیدگی ، بایستی حیوان را مشکوک به هاری تلقی نموده و اقدام های لازم را بلافاصله انجام داد تا خلاف آن ثابت شود و موضوع از نظر هاری منتفی گردد .لازم به ذکر است در هیچ شرایطی مجاز به تعویق و یا عدم تزریق واکسن هاری نمی باشیم .www.iehe.ir
اسلاید 51: پیشگیری از ابتلا به هاری در صورت وقوع حیوان گزیدگی (ادامه)زدودن و خارج کردن ویروس هاری از محل زخم: مهم ترین اقدام برای درمان پیشگیری از ابتلا به هاری است . می توان ادعا کرد که درصد بالایی از پیشگیری به رعایت کامل همین نکته مربوط است و اگر بتوان فوری و هرچه زودتر و در ساعات اولیه پس از گاز گرفتن اقدام موارد ذیل نمود کمک بسیار مؤثری در دفع و خارج کردن ویروس از زخم خواهد شد.شستشوی لابه لای زخم با آب تمیز و صابون حداقل به مدت 20 تا 15 دقیقه و به طور عمقیخارج کردن کف صابون از لابه لای زخم با استفاده از شیلنگ آب یا پیستوله آب پاش و جریان آب روان ؛ چراکه باقی ماندن صابون اثر بعضی مواد ضدعفونی کننده مورد استفاده پس از شستشو را خنثی می نماید www.iehe.ir
اسلاید 52: لازم است به مردم آموزش داده شود بلافاصله پس از حیوان گزیدگی زخم خود را شستشو دهند.www.iehe.ir
اسلاید 53: همکار محترم (پزشکی، پیراپزشکی ، دامپزشکی و... ) خواهشمند است پس از کشف افراد حیوان گزیده، قبل از هر عمل نسبت به شستشوی زخم (حتی خراش) اقدام نمایید و فرد را بلافاصله به مرکز بهداشت استان ارجاع فرمایید.www.iehe.ir
اسلاید 54: همکار محترم (پزشکی، پیراپزشکی، دامپزشکی و... ) بسیاری از مردم خطرات ناشی از عدم تزریق واکسن را باور ندارند ؛لذا لازم است قبل از ارجاع به مرکز بهداشت استان فرد را کاملا از عواقب سهل انگاری و عدم مراجعه جهت تزریق توجیه نموده، با دریافت نشانی فرد و گزارش آن به تلفن 7247080 در صورت عدم مراجعه فرد حیوان گزیده پیگیری امکان پذیر باشد.www.iehe.ir
اسلاید 55: زخم را می توان پس از استفاده از دستکش در وان، حوضچه یا کنار راه فاضلاب شستشو داد ؛پس از اتمام کار، شستشوی مکان فوق الذکر با آب و کمی مواد شوینده (پودر رخت شویی، صابون یا ... ) کافی است ؛ اگر مکان مذکور در معرض تابش آفتاب باشد بهتر است ونیازی به ضد عفونی ندارد.www.iehe.ir
اسلاید 56: پیشگیری از ابتلا به هاری در صورت وقوع حیوان گزیدگی (ادامه)قطع کامل قسمت های له شده و نکروزه ضدعفونی زخم با محلول بتادین یا الکل اتیلیک 40 تا 70 درصد و یا سایر مواد ویروس کشخودداری از بخیه زدن زخم حیوان گزیده : زیرا ویروس هاری بسیار حساس بوده و در مقابل نور و اکسیژن هوا ، قدرت بیماری زایی خود را از دست می دهد . البته در مورد زخم هایی که شریان های خونریزی دهنده دارند و یا جراحت هایی که موجب پارگی صفاق یا جنب یا عریان شدن استخوان می شوند ، می توان اقدام های ترمیمی شامل بخیه زدن شریان و سایر اقدام های لازم را توسط پزشک متخصص جراح انجام داد که در این صورت بایستی مقداری سرم هاری را در داخل و اطراف زخم اَنفیلتره نمود.www.iehe.ir
اسلاید 57: پیشگیری از ابتلا به هاری در صورت وقوع حیوان گزیدگی (ادامه) تزریق سرم ضد هاری : این سرم فقط به کسانی تزریق می شود که دارای یک یا چند گزیدگی یا خراش های عمیق جلدی (خراشی که در آن خون دیده شود) یا آلوده شدن غشای مخاطی با بزاق و یا خراش های سر ، صورت و گردن باشند. سرم ضد هاری مورد استفاده در ایران ، ایمنوگلوبولین اختصاصی ضد هاری تهیه شده از پلاسمای انسانی و بدون عارضه است و به تست هم نیازی ندارد .تزریق واکسن ضد کزاز ، توأم یا ثلاث : مطابق آخرین دستورالعمل ایمن سازی کشوریآنتی بیوتیک تراپی جهت پیشگیری از ابتلا به عفونتwww.iehe.ir
اسلاید 58: پیشگیری از ابتلا به هاری در صورت وقوع حیوان گزیدگی (ادامه)تزریق واکسن ضد هاری:واکسن مورد استفاده در ایران واکسن Vero (حاصل از کلیه نوعی میمون) است که بوسیله بتا پروپیولاکتن غیر فعال شده در ویال های تک دُزی لیوفیلیزه همراه با cc 5/0 حلال از مریو فرانسه خریداری می شود. این واکسن طی سال های زیادی که در ایران مصرف شده ، هیچ گونه عارضه و یا واکنش سوئی نداشته است.محل تزریق : به صورت عضلانی و حتماً در عضله دلتویید بازو ؛ در اطفال کمتر از دو سال باید در ناحیه فوقانی و جانبی ران تزریق شود و هرگز نبایستی سرین را انتخاب کرد.افرادی که پس از حیوان گزیدگی و دریافت 5 نوبت واکسن مجدداَ توسط حیوانی گزیده شوند ، تزریق سرم به آنان توصیه نمی گرددکسانیکه نیاز به سرم ضد هاری دارند ولی موجود نیست فقط تاروز هفتم می توان سرم را به آنها تزریق کرد و بعد از آن اجازه تزریق سرم را نداریم . www.iehe.ir
اسلاید 59: پیشگیری از ابتلا به هاری در صورت وقوع حیوان گزیدگی (ادامه)افرادی که قبلا واکسینه شده اند ؛ اگر دوباره توسط حیوانی گزیده شوند ، در صورتیکه فاصله واکسیناسیون قبلی و گاز گرفته شدن فعلی وی کمتر از 5 سال باشد ، تزریق دو نوبت واکسن در روزهای صفر و 3 الزامی است . اگر محل گاز گرفتن ، ناحیه سر و صورت است و یا فاصله واکسیناسیون قبلی و فعلی بیش از 5 سال باشد بایستی واکسیناسیون را دوباره شروع کرد.www.iehe.ir
اسلاید 60: تعداد نوبت های تزریق واکسن ضد هاریواکسن ضد هاری لازم است در3 یا 5 نوبت طبق شرایط ذیل تزریق گردد:(روزهای0/3/7/14/28) افراد حیوان گزیدۀ مشمول سه نوبت واکسن ضد هاری : در صورتیکه حیوان مهاجم فقط سگ یا گربه تحت نظر بوده و حیوان مهاجم 10 روز پس از گزش ، سالم (بدون علامتی از بیماری ) باشد می توان از ادامه واکسینایون خودداری نمود.در صورت دریافت نتیجه نهایی منفی آزمایش افراد حیوان گزیده مشمول پنج نوبت واکسن ضد هاری : تمامی حیوان گزیدگی ها بجز مورد فوقwww.iehe.ir
اسلاید 61: چنانچه سگ یا گربه مهاجم ، اهلی است یا در محل زندگی حضور دارد لازم است به مدت 10 روز تحت نظر قرار گیرد و در این مدت آب و غذای کافی در اختیار حیوان قرار داده شود؛ از طرفی جهت پیشگیری از آسیب سایر افراد، حیوان بسته شود ؛ در صورت سالم بودن سگ یا گربه مهاجم در طی این 10 روز ، سگ یا گربه مهاجم هار نبوده و می توان از ادامه واکسیناسیون خودداری نمود (در واقع تا مشخص شدن سلامت سگ یا گربه تحت نظر 3 نوبت واکسن به فرد حیوان گزیده تزریق می شود تا در صورت عدم سلامت سگ یا گربه مذکور زمان را از دست نداده باشیم) . www.iehe.ir
اسلاید 62: یادآور می گردد زمان 10 روز جهت تشخیص سلامت یا بیماری حیوان فقط در موردسگ وگربه صادق است و در خصوص سایر حیوانات اطلاعی در دست نمی باشد ؛ لذا در صورت گزیدگی توسط سایر حیوانات لازم است حتماً 5 نوبت واکسن بدون توجه به سلامت ظاهری حیوان مهاجم تزریق گردد .www.iehe.ir
اسلاید 63: تعداد نوبت های تزریق واکسن ضد هاری (ادامه)نوبت اول = روز صفر (مثال 21/1/86 ) نوبت دوم = روز 3 (مثال 24/1/86)نوبت سوم = روز 7 (مثال 28/1/86) نوبت چهارم = روز 14 (مثال 3/2/86) فروردین 31 روزه استنوبت پنجم = روز 30 (مثال 19/2/86)www.iehe.ir
اسلاید 64: پیشگیری از ابتلا به هاریواکسیناسیون کارکنان در معرض خطر هاری (ایمن سازی قبل از مواجهه) نظیر : کارکنان بخش درمان ÷یشگیری از هاری ،دامپزشکان ، تکنسین های دامپزشکی ، کارگران کشتارگاهها ، خدمه باغ وحش ، شکارچیان ، شکاربانان حفاظت محیط زیست ، مسئولان هاری و... به یکی از دو روش زیر:3 نوبت در روزهای 0/ 7 / 21 یا 283 نوبت در روزهای 0/ 28/ 56 (اگر مصون سازی فوریت ندارد) هر ساله یک نوبت یادآورچنانچه واکسیناسیون به منظور مسافرت به مناطق اندمیک بیماری هاری است ، شروع مسافرت باید حداقل یک ماه بعد از تزریق سومین نوبت واکسن انجام پذیردwww.iehe.ir
اسلاید 65: ابتلا به هاری=مرگ حتمیwww.iehe.ir
اسلاید 66: زمان، در پیشگیری از حیوان گزیدگی مهمترین رُکن در تعیین سرنوشت فرد حیوان گزیده است ؛ لذا اقدامات درمان پیشگیری (شستشوی زخم و واکسیناسیون با مراجعه به مرکز درمان پیشگیری از هاری ) بایستی بلافاصله پس از وقوع حادثه انجام شود .این نکته نیز قابل توجه است که فرد حیوان گزیده هر قدر با تأخیر کشف شود بایستی اقدامات درمان پیشگیری لازم (واکسیناسیون و...) ، فوری انجام شود.www.iehe.ir
اسلاید 67: شستشوی لابه لای زخم با آب و صابون و سپس آب خالصآموزش ، توجیه و تأکید بر لزوم تزریق واکسن ضد هاری و خطرات ناشی از عدم واکسیناسیونارجاع بیمار به همراه فرم ارجاع موارد فوری (از خانه های بهداشت و مراکز بهداشتی درمانی ) یا قطعه کاغذی حاوی نشانی تلفن مرکز درمان پیشگیری از هاری (از بیمارستان و ...)تماس با مرکز درمان پیشگیری از هاری و گزارش مشخصات فرد حیوان گزیده (نام و نام خانوادگی و نشانی و تلفن بیمار) جهت پیگیری در صورت عدم مراجعه فرد حیوان گزیدهخلاصه پیشگیری از ابتلا به هاری در صورت وقوع حیوان گزیدگیwww.iehe.ir
اسلاید 68: تزریق واکسن ضد هاری برای تمامی افراد حیوان گزیده بدون توجه به نوع حیوان ( خانگی، فانتزی ، اهلی، وحشی، ولگرد ، واکسینه یا غیر واکسینه) ضروری استwww.iehe.ir
اسلاید 69: مرکز درمان پیشگیری از هاری به صورت شبانه روزی (24 ساعته) حتی در روزهای تعطیل جهت تزریق واکسن ضدهاری افراد حیوان گزیده آماده خدمت می باشد. www.iehe.ir
اسلاید 70: تزریق واکسن ضد هاری برای تمامی افرادحیوان گزیدهبدون توجه به وسعت زخم( کَندگی ، له شدگی، پارگی حتی خراش یا ...)ضروری استwww.iehe.ir
اسلاید 71: بر اساس آخرین توصیه های WHO (سازمان بهداشت جهانی) آسیب دیدگان گاز گرفته توسط جوندگانی مانند موش خانگی ، موش صحرایی و خرگوش به درمان پیشگیری نیازی ندارند ؛ مگر در آینده از طرف انستیتو پاستور ایران گزارش های دیگری دال بر وجود بیماری در این حیوانات اعلام شود .درباره آسیب دیدگان گاز گرفته توسط موش خرما و راسو درمان پیشگیری ضروری استنکته : از آنجا که بسیاری از مردم در تشخیص حیوانات دچار اشتباه می شوند و اساساً انواع موشها را نمی شناسند و یا در گویش های مختلف نام حیوانات، متفاوت می باشد (به طور مثال مردم یک منطقه از قم به موش صحرایی ، موش خرما می گویند) لازم است از افراد حیوان گزیده که مُدعی اند توسط یکی از این حیوانات آسیب دیده اند مشخصات حیوان مهاجم سؤال و در صورت عدم اطمینان از نوع حیوان (موش خانگی، صحرایی،خرگوش با موش خرما، راسو و ...)، فوراً نسبت به درمان پیشگیری اقدامات لازم انجام پذیرد.www.iehe.ir
اسلاید 72: راهنمای درمان پیشگیری ضد هاری پس از مواجهه*در آلودگی به وسیله خرگوش و جوندگان صحرایی درمان ضد هاری به ندرت ضرورت می یابد . ** دوره تحت نظر بودن فقط برای سگ و گربه کاربرد دارد . جز مواردی که حیوان تهدید شده و در معرض خطر باشد ، سایر حیوان های اهلی و وحشی مشکوک به هاری باید به گونه ای مناسبی کشته شوند و به روش اختصاصی هاری بافت های آنها را آزمایش گردد . www.iehe.ir
اسلاید 73: نوعی از انواع موش صحراییموش خانگیراسوموش خرماwww.iehe.ir
اسلاید 74: تزریق واکسن ضد هاری برای تمامی افراد حیوان گزیده بدون توجه به گزش بدن عریان یا از روی لباس ضروری استwww.iehe.ir
اسلاید 75: شرایط نگهداری حیوانات صاحبداررعایت حقوق حیوانات:ایجاد مکان امن برای زندگی دور از دسترس دشمنان طبیعی حیواندارای سقف جهت جلوگیری از تابش مستقیم نور خورشید ، بارش آب باران ونفوذ سرما و گرمای شدیدتأمین آب و غذای کافیتربیت مناسب (تمامی حیوانات اهلی تربیت پذیر می باشند که با صرف وقت و حوصله تربیت لازم را خواهند پذیرفت ؛ از جمله خودداری از ورود به مناطق خاص و ...)نقاش : مریم امینی اصلآموزشگاه : زرین اقبالمربوط به مسابقه هاریwww.iehe.ir
اسلاید 76: قوانین نگهداری حیوانات صاحبدارشناسنامه دار کردن حیوانواکسیناسیون حیوان قلاده گذاری حیوان بستن حیوانبا توجه به وجود مشکلات بهداشتی ناشی از حیوانات (بخصوص سگ و گربه) از جمله بیماریهای هاری، کیست هیداتیک، توکسوپلاسموز ، بیماریهای انگلی روده ای؛ لیشمانیوز جلدی و احشایی و... و از آنجا که متأسفانه برخی صاحبان این قبیل حیوانات بدون هیچگونه احساس مسئولیتی ،حیوانات خود را رها و موجب ضرر و زیان بهداشتی ، جانی ، اقتصادی و ... در اطرافیان به ویژه همسایگان خود می گردند؛ لذا دولت قوانین 688 و 357 مجازات های اسلامی را جهت حمایت از سلامت مردم وضع نموده است .www.iehe.ir
اسلاید 77: قوانین مجازات های اسلامی ماده قانونی 688 مجازات های اسلامی: در صورت عدم رعایت قوانین فوق الذکر، صاحبان حیوان مشمول مجازات خواهند شد (هر اقدامی که تهدید علیه بهداشت عمومی شناخته شود ... مرتکبین ، چنانچه طبق قوانین خاص مشمول مجازات شدیدتری نباشند به حبس تا یک سال محکوم خواهند شد ) از آنجا که در خصوص این قانون ارگانهای دولتی ذیربط می توانند مدعی العموم باشند و از طرفی شکایات مردمی بسیار زیاد و موارد حیوان گزیدگی بالا ست در حال حاضر مرکز بهداشت استان ها در حال فرهنگ سازی جهت اجرای این قوانین در کلیه روستاهای استان می باشد که البته حمایت سایر مسئولین استانی و از همه مهمتر خود مردم را می طلبد؛ لازم به ذکر است در برخی روستاها علیرغم مخالفت های شدید صاحبان سگ ها و سایر موانع موفقیتهای چشمگیری دیده شده است که همکاری مسئولین آن مناطق (شوراها ، قضات و ...) را نمی توان نادیده گرفت.ماده قانونی 357 مجازات های اسلامی: صاحب هر حیوانی که خطر حمله و آسیب رسانیدن آن را می داند باید آن را حفظ و کنترل نماید و اگر در اثر اهمال و سهل انگاری موجب تلف و خسارت گردد صاحب حیوان عهده دار خسارت مربوطه می باشد ؛ لذا فرد آسیب دیده می تواند شخصاً در دادگاه ، ادعای خسارت نماید (البته نه دلیل مالی، بلکه به جهت جلوگیری از تکرار حادثه و ایجاد احساس مسئولیت در صاحب حیوان).www.iehe.ir
اسلاید 78: مضرات رها بودن حیوانات اهلی بخصوص سگ و گربهورود به دنیای وحوش (خارج از اماکن انسانی) و تماس با آنها و افزایش احتمال ابتلا به بیماریهای واگیردار جلب وحوش به اماکن انسانی و خطر انتقال بیماریهای واگیردار به انسانمصرف پس مانده های غذایی آلوده حمله به اطرافیان و انتقال آلودگی و بیماریwww.iehe.ir
اسلاید 79: افراد گاز گرفته توسط سگ واکسینه به علت عدم اعتماد به ایمنی و امکان انتقال بیماری هاری، باید حتماً تحت درمانْ پیشگیری از هاری قرار گیرند.افراد گاز گرفته توسط سگ یا گربه خانگی حتی از نوع فانتزی ، بایستی باز هم واکسن ضد هاری را دریافت دارند (هرچند شواهدی دال بر خروج حیوان از منزل وجود نداشته باشد).www.iehe.ir
اسلاید 80: آموزش، در پیشگیری از هاری بسیار مهم است ؛ چه بسا بسیاری افراد راههای پیشگیری از بیماری را نمی دانند و متأسفانه رعایت نکات پیشگیری، برای بسیاری از افراد پوچ و مسخره (مانند مراجعه جهت تزریق واکسن به علت پنجه کشیدن گربه که ایجاد خراش شده است) و برای عده ای دیگرغیر ممکن (مانند بستن سگ ها ) و یا حتی غیر ضروری به نظر می رسد ؛ بنابراین: در صورت مشاهده افراد حیوان گزیده ، لازم است لزوم تزریق واکسن و خطرهای احتمالی ناشی از عدم تزریق واکسن هاری ( احتمال ابتلا به هاری و مرگ حتمی افراد مبتلا به هاری) به کونه ای توضیح داده شود که فرد حیوان گزیده خود اقدام به مراجعه جهت تزریق واکسن نماید.www.iehe.ir
اسلاید 81: موفق باشیدwww.iehe.ir
خرید پاورپوینت توسط کلیه کارتهای شتاب امکانپذیر است و بلافاصله پس از خرید، لینک دانلود پاورپوینت در اختیار شما قرار خواهد گرفت.
در صورت عدم رضایت سفارش برگشت و وجه به حساب شما برگشت داده خواهد شد.
در صورت بروز هر گونه مشکل به شماره 09353405883 در ایتا پیام دهید یا با ای دی poshtibani_ppt_ir در تلگرام ارتباط بگیرید.
- پاورپوینتهای مشابه

نقد و بررسی ها
هیچ نظری برای این پاورپوینت نوشته نشده است.